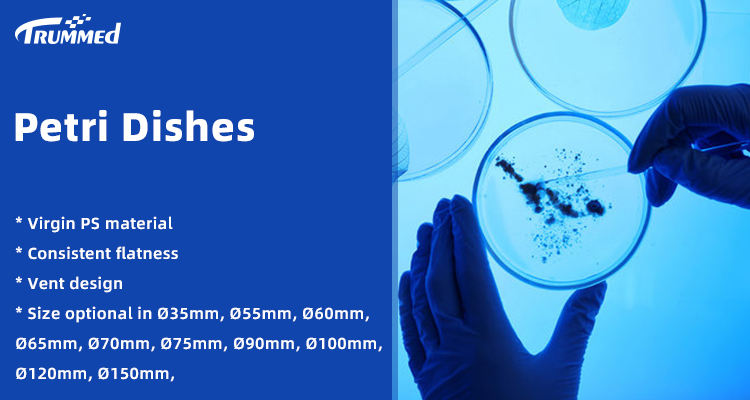

Assorted Types of Petri Dishes with Ventilation Design 90mm Sterile Petri Dish with 1/2/3/4 Compartments
-
Supplier: Trummed Medical (hangzhou) Co., Ltd. -
Region: Zhejiang, China -
Contact: Ms Shalldan Fang -
Price: $0.03 / >=5000 pieces -
Min. Order: 5000 pieces
Product details
| port: | Shanghai, Ningbo | size: | 90x15mm |
| brand: | bulging | Material: | Virgin PS |
| color: | transparent | place of origin; place of origin: | Zhejiang, China |
| Supply capacity: | 1,000,000 pieces per day | Types of: | 1/2/3/4 rooms and 3 vents |
| payment terms: | L/C, Western Union, T/T, MoneyGram, PayPal | Warranty: | 3 years |
| Customization support: | OEM,ODM,OBM | Classification: | petri dish |
| Packaging Details: | Sealed bag, 10pcs/bag, 500pcs/ctn | product name: | petri dish |
| application: | chemistry lab | grid: | No |
| Sterile: | Ethylene oxide | shape: | round |
| model: | 161-0902/161-0904/161-0905/161-0906 |
Product Description
Petri dishes are laboratory utensils used to grow microorganisms or cells. It can be used for laboratory inoculation, streaking, bacterial isolation operations and plant germination. *Made of virgin PS material*Transparent PS material is easy to observe and more convenient for experimentation*Venting hole design for easy air exchange*Easy to stack with stacking rings. * The bottom of the petri dish is smooth and clean without deformation * EO or Gamma radiation sterilization is available

VIEW MORE
You may like
-
Laboratory disposable transparent plastic culture dish 100mm 90mm sterile culture culture dish 90x15mm

-
Factory price disposable cell culture sterilization 1 room 2 room 3 room 90*15mm culture dish

-
Glass petri dishes

-
HAIJU LAB Glass Different Size Borosilicate Glass Petri Dish with Lid

-
Sterile disposable plastic 90x15mm two-chamber petri dish 60mm 35mm 150mm

-
Different Types of Manufacturing Price Disposable Medical pp Sterile Petri Dish

-
Disposable sterile plastic plates 90x15mm Agar 9cm Petri dishes

-
Laboratory AKMLab Polystyrene with high transparency 35mm 60mm 100mm 150mm Petri Dish

-
Wholesale EO Sterile 90mm 150mm 15cm Laboratory Disposable Bacterial Tissue Culture Plate Plastic Petri Dish With Lid

-
bulk sterile reusable plastic agar square quartz 90mm 200mm petri dish dish with CE ISO












